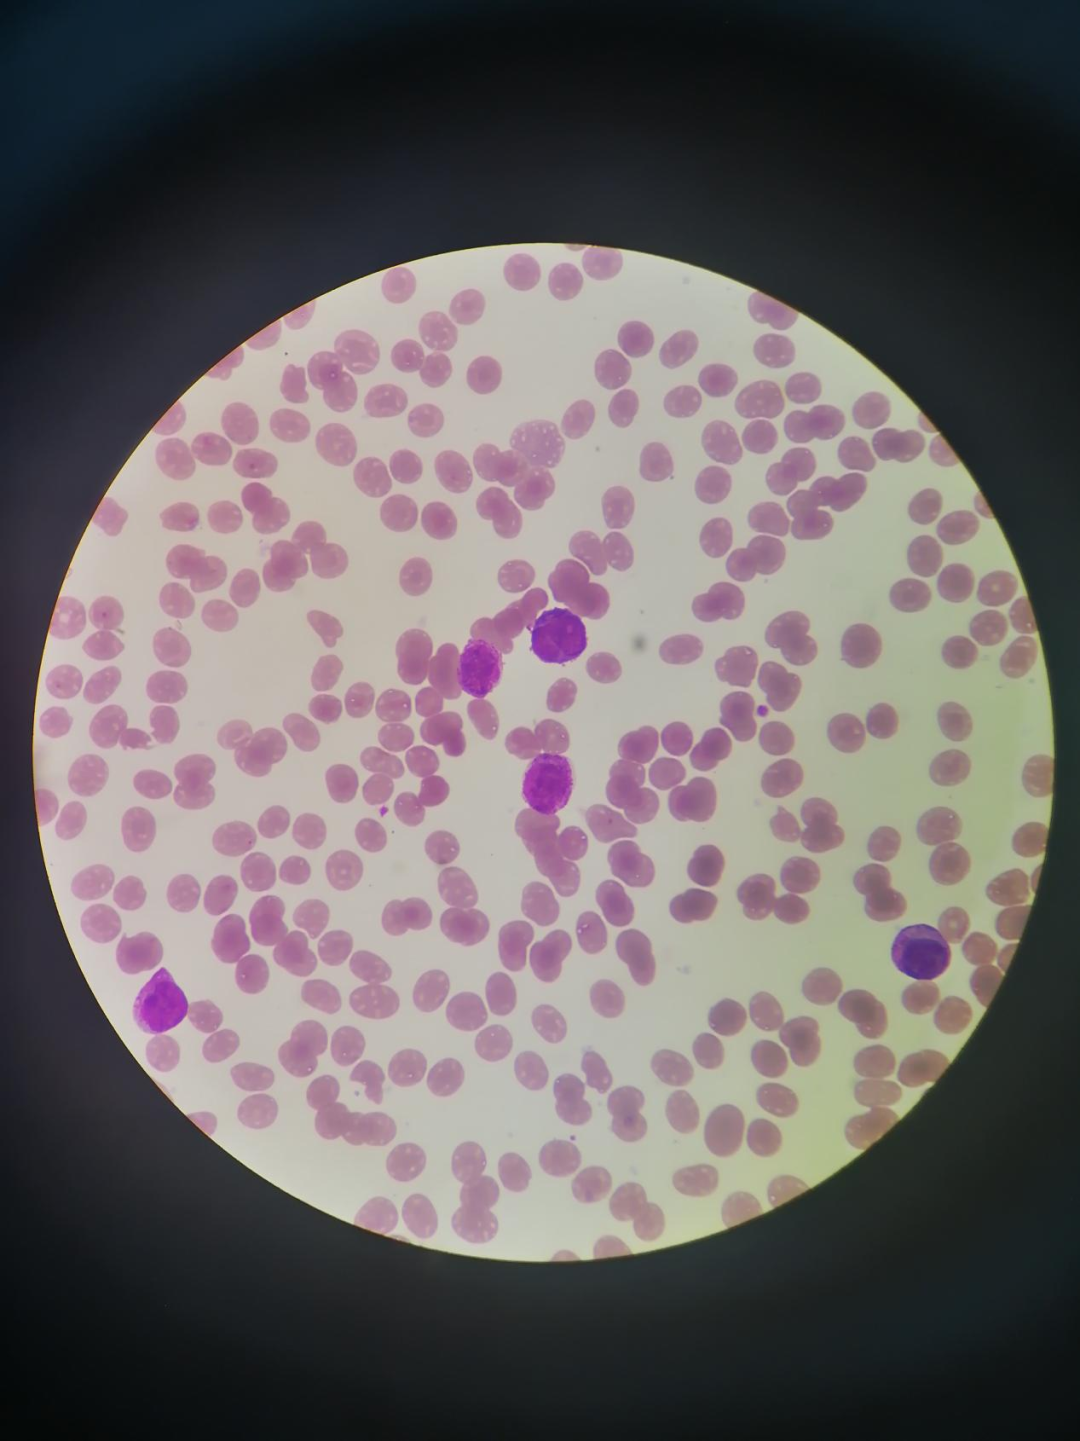
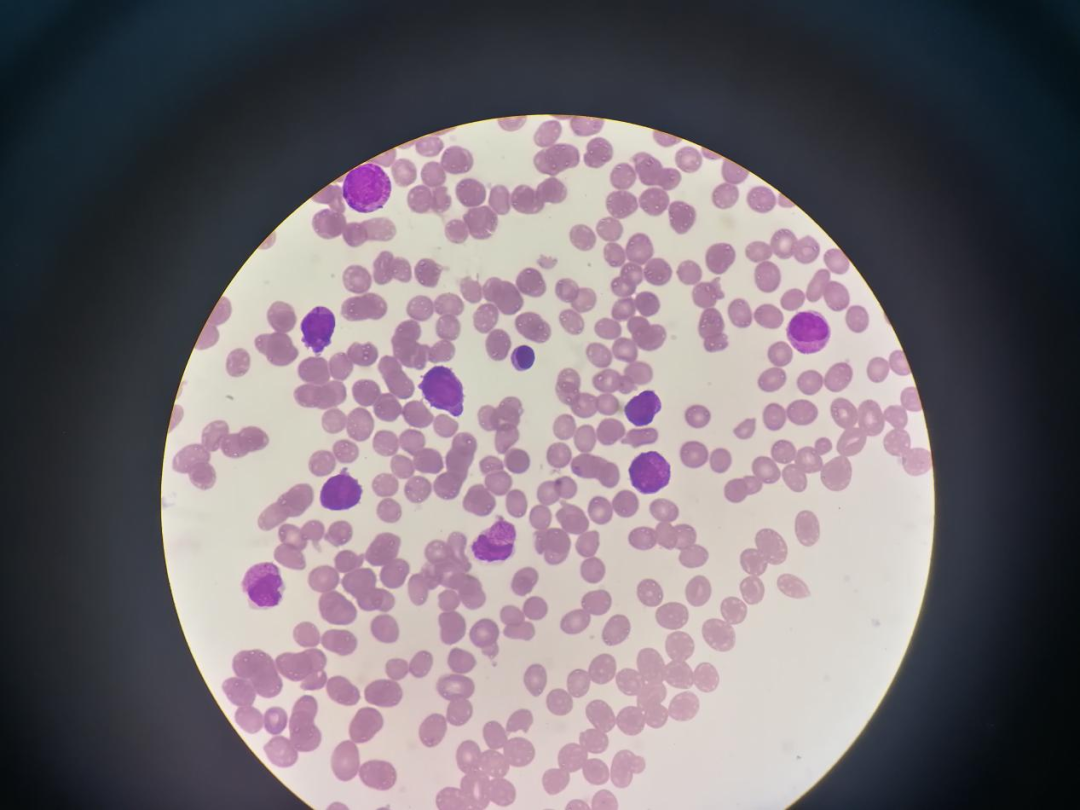

【案例分享】一例急性早幼粒细胞白血病
患者,女,26岁,2021年6月27日出现头痛、头晕、伴发热(最高体温40℃)症状,曾到其他医院就医。28日症状有所好转,29日仍有头痛、呕吐,四肢乏力伴发热。30日凌晨到本院就诊
血常规如下图:
血常规白细胞中单核细胞百分比升高,22.20%,散点图出现灰区,可能是仪器对幼稚细胞分类不了。
其他生化、凝血结果异常如下图:


凝血功能异常,出现DIC现象
外周血涂片形态学见图:

外周血涂片见大量早幼粒细胞,并可在胞浆见到柴捆样细胞,这是AML-M3的标志。


该病例最后诊断为急性早幼粒细胞白血病,因患者病情危重,进展快,出现电解质代谢紊乱、急性肾衰竭,脑功能损害,中枢性呼吸循环衰竭,虽经积极救治,但最终于2021年7月4日04时00分死亡。
M3简述:
●骨髓中以颗粒增多的早幼粒细胞为主●典型表现为贫血、出血、感染等
●维甲酸+砷剂是首选治疗方案
●完全缓解率和五年无病生存率较高
急性早幼粒细胞白血病是急性髓系白血病(AML )的一种类型↓FAB分型 (一种急性白血病的分型诊断标准)为M3型,其特点是骨髓中以颗粒增多的早幼粒细胞为主,此类细胞在骨髓非红系有核细胞中的计数大于等于30%。
疾病类型:
●粗颗粒型(M3a) :骨髓早幼粒细胞胞弥颗粒相大、密集或融合,
●细颗粒型(M3b) : 骨髓早幼粒细胞颗粒细小而密集。
●微颗粒型(M3c ) :周围血早幼粒细胞颗粒甚少或缺如,而骨髓中仍为典型的早幼粒细胞。
文章作者:广东省阳江市中医医院


